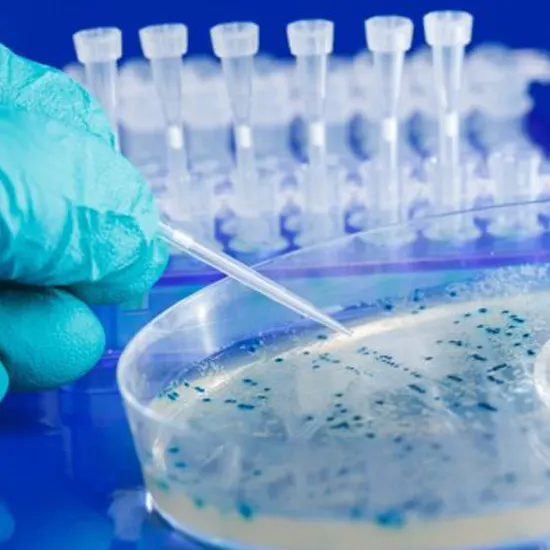

Book Urine For AFB Appointment Online Near me at the best price in Delhi/NCR from Ganesh Diagnostic. NABL & NABH Accredited Diagnostic centre and Pathology lab in Delhi offering a wide range of Radiology & Pathology tests. Get Free Ambulance & Free Home Sample collection. 24X7 Hour Open. Call Now at 011-47-444-444 to Book your Urine For AFB at 50% Discount.
Destructive fast bacillus is a sort of organism that causes TB and unequivocal disparate sicknesses.
It can moreover impact various bits of the body, including the frontal cortex, backbone, and kidneys. TB is spread from one individual to another through hacking or sniffling.
Your medical care supplier will require an example of your sputum for both an AFB stain and an AFB couth. The two tests are normally done simultaneously.
You will be approached to hack profoundly and spit into a sterile compartment. You should do this for a few days straight. This helps ensure your example has an adequate number of microscopic organisms for testing.
Assuming you experience difficulty hacking up sufficient sputum, your supplier might request that you take in a clean saline (salt) fog that can assist you with hacking all the more profoundly.
No planning is vital for this test.
Assuming that your outcomes on an AFB smear or culture were negative, you presumably don't have dynamic TB.
Assuming that your AFB smear was optimistic, it implies you presumably have TB or other contamination, yet an AFB culture is expected to affirm the analysis
Assuming that your AFB culture was optimistic, it implies you have dynamic TB or one more sort of AFB contamination. The way of life can recognize which sort of disease you have
You might require the test on the off chance that you have side effects of dynamic TB. These include:
>>There are no dangers with this test.
>>Nothing explicitly
Urine for AFB test in Delhi is at ₹ 160.0
| Test Type | Urine For AFB |
| Includes | Urine for AFB (Pathology) |
| Preparation | |
| Reporting | Within 24 hours* |
| Test Price |
₹ 350
|

Early check ups are always better than delayed ones. Safety, precaution & care is depicted from the several health checkups. Here, we present simple & comprehensive health packages for any kind of testing to ensure the early prescribed treatment to safeguard your health.